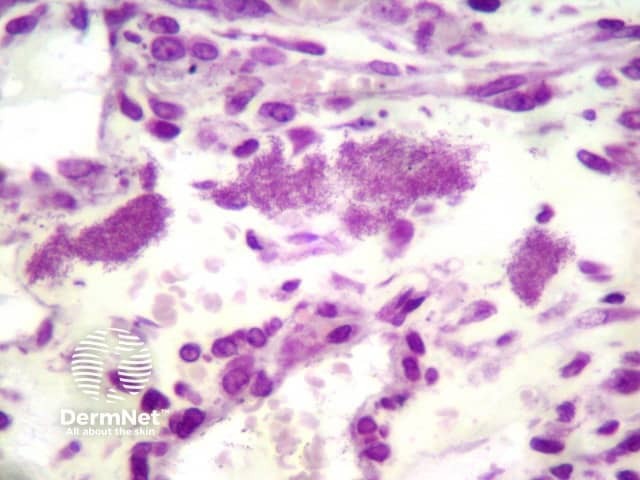
Figure 3

Main menu
Common skin conditions
NEWS
Join DermNet PRO
Read more
Quick links
Infections Diagnosis and testing
Author: Assoc Prof Patrick Emanuel, Dermatopathologist, Auckland, New Zealand, 2013.
Introduction Histology Special stains Differential diagnoses
Bacillary angiomatosis is caused by the Rickettsia-like organism, Bartonella henselae.
Histologically, the lesions of bacillary angiomatosis closely resemble pyogenic granuloma. Typically, there are ulcerated papules or nodules composed of lobules of highly vascularised oedematous connective tissue (Figure 1). There is typically a mixed-cell infiltrate and nuclear dust of degenerated inflammatory cells. Accompanying this peculiar background are diagnostic clumps of pink-purplish granular material (Figure 2). This granular material consist of huge numbers of the gram-negative rods of Bartonella (Rochalimaea) henselae (Figure 3).

Figure 1

Figure 2
Figure 3
Warthin-Starry stain or gram stain highlight the pink-purple clumps of bartonella organisms. The organisms are revealed to be gram-negative rods with gram stain (Figure 3).
Pyogenic granuloma – This also shows an ulcerated lobulated vascular proliferation and inflammatory changes. The organisms are an obvious clue. In organism-poor cases fragmented inflammatory cells can be an important clue and prompt further microbiologic studies.
Verruga peruana – This disease is practically indistinguishable from bacillary angiomatosis histopathologically and similar clumps of bacteria may be found. This disease occurs in Peru and some other parts of South America and is caused by an infectious agent, Bartonella bacilliformis, a relative of Bartonella henselae.